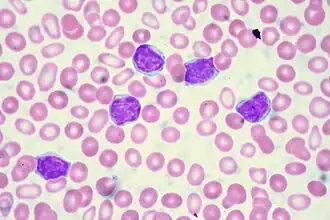

Lymfoidní progenitor

Lymfoidní progenitor (common lymphoid progenitor, CLP) je lymfoidní multipotentní buňka v kostní dřeni vznikající z multipotentního progenitoru vznikajícího z pluripotentní hematopoetické kmenové buňky, dávající v průběhu hematopoezy (krvetvorby) vznik T-lymfocytům, B-lymfocytům a NK buňkám (natural-killer cells). [1]
Regulace
Regulace přežití buňky a buněčného růstu v průběhu hemato-lymfopoézy je primárně zajišťována cytokiny. Cytokinová signalizace je kritickým krokem k diferencianci buňky do lymfoidní linie. Lymfoidní progenitory mohou být přesměrovány k vývoji do myeolidní řady stimulací receptorů skrze exogenní expresi interleukinu (IL)-2 a GM-CSF (granulocyte/macrophage colony-stimulating factor). Signalizační dráhy jsou oddělené, čehož důkazem je spouštění diferenciace do granulocytů a monocytů různými cytoplazmatickými doménami. Endogenní myelomonocytové cytokinové receptory pro GM-CSF (granulocyte/macrophage colony-stimulating factor) a M-CSF (macrophage colony-stimulating factor) na lymfoidních progenitorech nejsou, u myeloidních jsou transkribovány až po indukci do myeloidní linie prostřednictvím IL-2. [1]
Rozlišení
Rozlišení velmi malých lymfoidních progenitorů je možné díky vícebarevné průtokové cytometrii a použití genetických markerů. Lymfoidní progenitory mají poměrně různorodé vlastnosti, jedna skupina má potenciál vytvořit jednotlivou linii (například T-lymfocytů), ovšem velmi rané progenitory si mohou zachovat určitý stupeň plasticity. To znamená, že jejich částečná progrese nevylučuje "přeprogramování" k jinému osudu. [2]
Spojitost s leukémií
Akutní lymfoblastická leukémie (ALL) tvoří 80% všech leukémií, přičemž průběh se liší v dětském a dospělém věku. ALL v dětském věku je důsledek opakovaného poškození chromozomální výbavy lymfoidního progenitoru, spolu s působením běžných bakteriálních a virových infekcí na které je ALL abnormální odpovědí. Leukémie z prekurzorů B lymfocytů tvoří 85% všech ALL, leukémie z prekurzorů T lymfocytů tvoří pak 15%. Druhým typem lymfoblastické leukémie je pak chronická lymfatická leukémie (CLL). [3]
Reference
- ↑ a b Motonari Kondo, David C. Scherer, Toshihiro Miyamoto, Angela G. King, Koichi Akashi, Kazuo Sugamura, Irving L. Weissman. Cell-fate conversion of lymphoid-committed progenitors by instructive actions of cytokines. Nature. 2000, s. 383-386. doi:10.1038/35030112.
- ↑ Rosana Pelayo, Rob Welner, S Scott Perry, Jiaxue Huang, Yoshihiro Baba, Takafumi Yokota and Paul W Kincade. Lymphoid progenitors and primary routes to becoming cells of the immune system. Current Opinion in Immunology. 2005, s. 100-107. doi:10.1016/j.coi.2005.01.012.
- ↑ STARÝ, Jan. Leukemie v dětském věku [online]. 1.11.2006, rev. 3.1.2011 [cit. 2012-04-26]. Dostupné online.